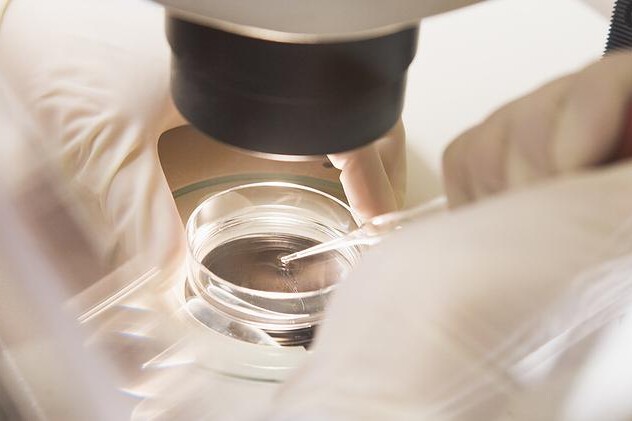
Léčba ženské neplodnosti

Dehydratace je nedostatek tekutin v těle. Ohrožuje především děti a staré lidi.

Léčba ženské neplodnosti přímo závisí na její příčině. Neplodnost způsobená nerovnováhou hormonů lze řešit podáváním příslušných léků, které navodí pravidelnou ovulaci. Srůsty na vejcovodech, popřípadě cysty, se dají řešit chirurgicky. Pokud však předchozí léčby selhaly nebo nejsou možné, užívají se metody asistované reprodukce, mezi které patří oplodnění in vitro, intracytoplazmatická injekce a nitroděložní inseminace.
Neplodnost bývá definována jako neschopnost počít dítě, při pravidelném nechráněném pohlavním styku, trvající déle než rok, někteří odborníci uvádějí déle než dva roky. Léčba ženské neplodnosti závisí na vyvolávající příčině. Za ženskou neplodnost může řada příčin, mezi které patří hormonální porucha, porucha vaječníků, poškození vejcovodů, endometrióza, abnormality a poruchy dělohy, vývojové vady genitálu, zánět pochvy, porucha funkce imunitního systému a psychické vlivy. Dále jsou známy také faktory, které ovlivňují plodnost a jimi jsou věk, negativní vlivy prostředí ovzduší, kouření, alkohol, drogy, sexuální aktivita, vrozené vady a získaná onemocnění a výživa. Níže se podrobněji podíváme na léčbu nejčastějších příčin ženské neplodnosti.
Pro ženskou plodnost je důležitá pravidelná ovulace, při které se uvolní jednou za měsíc při tzv. menstruačním cyklu z vaječníků vajíčko. Tento proces je řízen a kontrolován hormony. Těch důležitých je několik. V hypothalamu, což je část mozku, se tvoří gonadoliberin. To je hormon, který hlídá uvolňování dalších hormonů, folikuly stimulujícího hormonu (FSH) a luteinizačního hormonu (LH), z jiné části mozku zvané hypofýza. Tyto hormony jsou krví roznášeny v organismu a působí na vaječníky. Ve vaječnících se pod vlivem těchto působků tvoří ještě další hormony, tedy progesteron a estrogen. Všechny tyto hormony mají při rozmnožování podstatný úkol, a to zajistit, že ve vaječníku jednou za měsíc dozraje vajíčko schopné oplození a že pohlavní orgány ženy budou připraveny na přijetí spermie a na uhnízdění oplozeného vajíčka. Ovlivňují složení hlenu, který je jinak pro spermie neprostupný, a také kvalitu sliznice v děloze.
Jelikož je proces zajišťující ženskou plodnost tak složitý, může se stát, že v jeho řízení dojde k chybě. Naštěstí v dnešní době máme možnosti, jak docílit, aby žena pravidelně ovulovala. Prvním krokem v léčbě ženské neplodnosti tedy je snaha dosáhnout přirozené hladiny hormonů. Nejprve zkoušíme ovlivňovat první hormon v řadě, tedy gonadoliberin. Jeho vysoké nebo naopak nízké hladiny mohou způsobit, že se správně neuvolňují další hormony a tedy nedochází k vyzrávání vajíčka. Uvolňování gonadoliberinu můžeme podpořit lékem, který se nazývá klomifen citrát. Po této léčbě většina žen spontánně otěhotní. Pokud ale ne, přichází se k dalšímu kroku. A tím je podání folikuly stimulujícího hormonu (FSH) a luteinizačního hormonu (LH), které jsou přirozeně uvolňovány hypofýzou, tedy podvěskem mozkovým. Ty působí přímo na vaječníky a ovlivňují vyzrávání vajíček.
Příčinou ženské neplodnosti může být také neprůchodnost vejcovodů, díky které nemůže spermie k vajíčku nebo oplozené vajíčko do dělohy. Na vině jsou také srůsty mezi orgány podbřišku, které vznikají vlivem dlouhodobých zánětů či operačního zákroku. Mají své chirurgické řešení. Při jednoduché operaci se srůsty rozruší a na jejich místech se použijí protisrůstové přípravky, aby se situace už nemohla opakovat. Lékaři se mohou pokusit i o znovuzprůchodnění ucpaných vejcovodů. Chirurgicky se řeší i nádory vaječníků, vejcovodů a dělohy, které mohou mít negativní vliv na plodnost. Odstraňuje se také endometrióza neboli přítomnost děložní sliznice mimo dělohu, nejčastěji na vaječnících, vejcovodech a močovém měchýři. Tato sliznice, stejně jako sliznice v děloze, podléhá vlivu hormonů a v období menstruace zde dochází ke krvácení, které postupně vede k jizvení v místě endometriózy a vzniku srůstů.
Při léčbě ženské neplodnosti je důležité eliminovat všechny nepříznivé faktory, které ženskou plodnost ovlivňují. Důležité je, aby žena měla ideální váhu. Nadváha či naopak podvýživa vedou k poruchám ovulace a tím k neplodnosti. Kouření, alkohol a drogy mají též negativní vliv na plodnost. Dále důležitým rizikovým faktorem je věk. Se stoupajícím věkem ženě postupně klesá schopnost otěhotnění a stoupá riziko komplikací. Uvádí se, že nejoptimálnější věk na početí je kolem 25let. Ženskou neplodnost ovlivňuje také psychická nevyrovnanost. V některých případech se nenajde tělesná příčina neplodnosti a až psychoterapie pomůže ženě otěhotnět. Také je třeba pravidelně navštěvovat svého lékaře, který dělá preventivní prohlídky. Ten může zjistit například cukrovku nebo sníženou funkci štítné žlázy, které se mohou podílet na ženské neplodnosti. Je vhodné včas léčit gynekologické záněty a pohlavně přenosné choroby.
Pokud ani po všech těchto krocích žena přirozeně neotěhotní, jsou na řadě metody asistované reprodukce. Mezi ně patří intrauterinní inseminace, in vitro fertilizace, intracytoplazmatická injekce spermie. Nejjednodušším způsobem je intrauterinní neboli nitroděložní inseminace neboli IUI, při které se spermie partnera přenesou do dělohy ženy, a tím se jim zkrátí cesta a riziko, že zahynou, než se dostanou k vajíčku. Další variantou je in vitro fertilizace neboli IVF, při které se odebere vajíčko a spermie muže a mimo těla partnerů se pod mikroskopem nechají oplodnit. Poté se oplodněné vajíčko vrátí zpět do dělohy. Pokud ani tato metoda nevyjde, je zde možnost tzv. intracytoplazmatické injekce, při které se pod mikroskopem pouze jedna kvalitní spermie aplikuje tenkou jehlou přímo do vajíčka. Takto vzniklý zárodek se vrací ženě do dělohy, kde se může přirozeně vyvíjet.